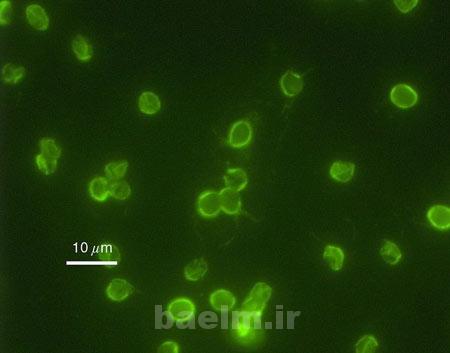
میکرو ارگانیسم,میکرو ارگانیسم های غیر بیماری زا,باکتری های موجود در آب میکرو ارگانیسم,میکرو ارگانیسم های غیر بیماری زا,باکتری های موجود در آب

میکرو ارگانیسم ها و باکتری های زیادی درون آبها زندگی می کنند که بعضی از آنها بی ضرر و برخی اگر از بین نروند باعث به خطر انداختن سلامت می شوند.
1- کریپتو سپوریدیوم:
در آب دریاچه ها و رودخانه ها باکتری های زیاد وجود دارند که اگر از روش های پیشرفته فیتراسیون انجام نشود انگل و برخی از باکتری ها هنوز در آب باقی می مانند.
2- سیانو:
سیانو یک باکتری چند سلولی است که در آب های آشامیدنی رشد می کند و در استرالیا و اروپا و برخی از مناطق آسیا این باکتری درون برخی از آبهای لوله کشی زندگی می کند و تاکنون باعث مرگ و میرهای زیادی شده است.

3- روتیفرز:
یک میکرو ارگانیسم نسبتا شایع است که تقریبا در همه جای جهان یافت می شود و شایع ترین آلاینده آب های آشامیدنی به شمار می آید و فیتراسیون های قوی تنها قادر به از بین بردن آن هستند.

4- کوپپودز:
یک انگل از سخت پوستان است که بر اثر آلوده کردن آب های آشامیدنی توسط مردم، کارخانه ها و ورود آلاینده ها به آب ها به وجود می آید و از طریق سیستم تصفیه به قطعات ریز تبدیل می شود.

5- اشرشیالکی

6-باکتری لژیونلا:
این باکتری که بر روی موبایل ها نیز وجود دارد هر ساله باعث مرگ و میر زیادی از مردم می شود و در آب های آلوده و آب های آشامیدنی شهری به وفور یافت می شود و استفراغ، اسهال و دردهای عضلانی از شایعترین دردهای معروف این آب هستند.

7- چتومیوم:
این باکتری که از طریق هوا در مکان های مرطوب وارد آب های آشامیدنی می شود بیشتر در آب های آشامیدنی در مناطق ساحلی وجود دارد و طعم و مزه آب را به نمکی تغییر می دهد.

8 باکتری سالمونلا:
سالمونلا تقریبا در تمام آب های آشامیدنی وجود دارد و باعث شیوع بیماری های زیاد می شود و این باکتری در کشورهای در حال توسعه بسیار وجود دارد.

منبع:yjc.ir
